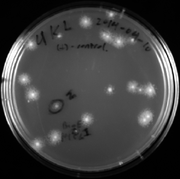
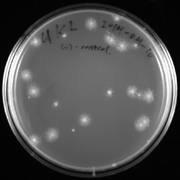

Uploads by Kelvin Li
From OpenWetWare
Jump to navigationJump to search
This special page shows all uploaded files.
| Date | Name | Thumbnail | Size | Description |
|---|---|---|---|---|
| 04:50, 7 May 2014 | SBB14 2014-05-02 gel.enhanced.png (file) |  |
208 KB | |
| 04:50, 7 May 2014 | SBB14 2014-05-02 tube.enhanced.jpg (file) |  |
178 KB | |
| 08:22, 2 May 2014 | SBB14 2014-05-01 plate pick.enhanced.png (file) |  |
343 KB | |
| 08:22, 2 May 2014 | SBB14 2014-05-01 plate.enhanced.png (file) |  |
267 KB | |
| 02:28, 23 April 2014 | SBB14 2014-04-22 gel.enhanced.png (file) |  |
165 KB | |
| 05:34, 16 April 2014 | 2014-04-15 plate.enhanced.png (file) | |
190 KB | |
| 04:44, 15 April 2014 | 2014-04-11 plate good.enhanced.png (file) | |
288 KB | |
| 03:54, 4 April 2014 | SBB14 gel Kelvin 2014-04-03.enhanced.png (file) |  |
131 KB | |
| 00:39, 2 April 2014 | SBB14 gel Kelvin 2014-04-01.enhanced.png (file) |  |
27 KB | |
| 04:39, 27 March 2014 | SBB14 gel 2014-03-20 Kelvin Tae.enhanced.jpg (file) |  |
62 KB | |
| 04:15, 18 March 2014 | SBB14 gel Karim Kelvin 2014-03-13.enhanced.jpg (file) |  |
66 KB | |
| 23:44, 7 March 2014 | SBB14 gel Tae Kelvin 2014-03-07.enhanced.jpg (file) |  |
84 KB | Gel visualization of Tae's and Kelvin's SOE'ing PCR products on 2014-03-07 for SBB14. Bands were subsequently cut out. Image was annotated and contrast-enhanced. |
| 18:32, 18 February 2014 | Thermotoga maritima MSB8.gb (file) | 4.21 MB | Thermotoga maritima MSB8 genome (Genbank format). Source: www.ncbi.nlm.nih.gov/nuccore/AE000512 |